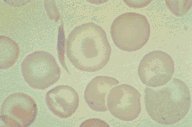

Description
This high oil magnification view is from a patient with sickle
thalassemia disease. A sickled cell is seen, as is classic target
cell in the center of the field. There is some anisocytosis and
poikilocytosis, as well as some faint basophilic stippling in
one cell.
|
|
Click on this image
to enlarge it, then
on Back buttom
in the Netscape Menu
to shrink it back down



|